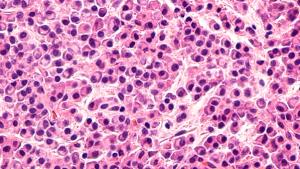

Hypogammaglobulinemia was found to be nearly universal for patients with multiple myeloma during treatment with daratumumab, suggesting a role for intravenous immunoglobulin.

Your AI-Trained Oncology Knowledge Connection!


Hypogammaglobulinemia was found to be nearly universal for patients with multiple myeloma during treatment with daratumumab, suggesting a role for intravenous immunoglobulin.

A study of the use of intravenous immunoglobulin on infections in patients with multiple myeloma receiving daratumumab suggested a role for the strategy in this patient population.

Guido Lancman, MD, sought to evaluate the effect of intravenous immunoglobulin on infections in patients with multiple myeloma receiving daratumumab.

A study of the effect of intravenous immunoglobulin (IVIG) on infections in patients with multiple myeloma receiving daratumumab indicated that hypogammaglobulinemia was nearly universal during treatment, suggesting a role for IVIG.

The hematology and oncology fellow at the Icahn School of Medicine at Mount Sinai discussed which patient groups he believes require more attention.

The hematology and oncology fellow at the Icahn School of Medicine at Mount Sinai highlighted multiple myeloma treatments that he believes have shown promise over the past year.

The hematology and oncology fellow at the Icahn School of Medicine at Mount Sinai discussed exciting treatment options for patients with multiple myeloma that are being presented at ASH this year.
Published: December 13th 2020 | Updated:

Published: December 17th 2020 | Updated:

Published: December 10th 2020 | Updated:

Published: December 26th 2020 | Updated: